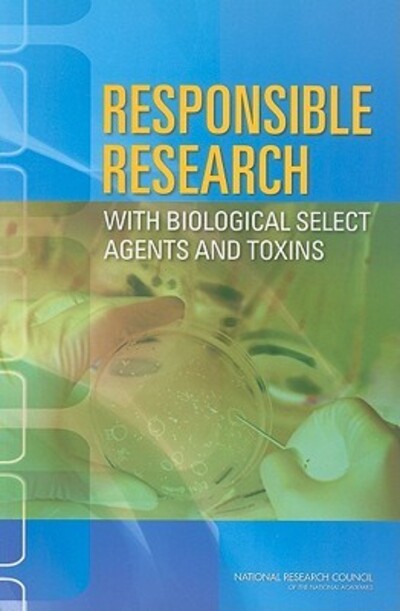

Currently Out Of Stock
Responsible research
Paperback
€53.65
Collect 160 Reward Points
- Currently Out Of Stock
- Product Details
-
- ISBN
- 9780309145350
- Format
- Paperback
- Publisher
- National Academies Press, (12 January 2010)
- Number of Pages
- 170
- Weight
- 316 grams
- Language
- English
- Dimensions
- 156 x 227 x 14 mm
- Categories: